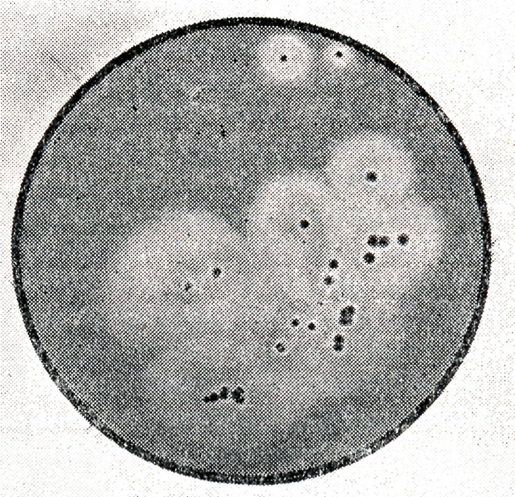

Ботулизм |
||
 |
 |
Оглавление
|
БотулизмБотулизм (лат. botulus колбаса; син. аллантиазис) — тяжёлая интоксикация, возникающая в результате употребления в пищу продуктов, содержащих токсины Clostridium Botulinum, и характеризующаяся преимущественным поражением центральной и вегетативной нервной системы. Статистика. Существующая статистика не отражает истинных размеров заболеваемости людей Б. Она более достоверна и полна там, где осуществляется детальное лабораторное обследование всех острых и смертельных случаев заболеваний, и практически отсутствует во многих странах, где случаи смерти не подвергаются экспертизе и не имеется условий для госпитализации больных. Даже в развитых странах только за последние десятилетия эту группу тяжёлых интоксикаций стали дифференцировать по типам токсинов, обусловивших их развитие, что является непременным условием для своевременного и правильного лечения больного. Майер (К. Meyer, 1956), анализируя заболеваемость Б. в мире за 50 лет, полагает, что за этот период заболело 5635 чел., из к-рых 1714 умерли. Эта статистика основана на отдельных публикациях. В США за 65 лет (1899—1964) зарегистрировано 1574 заболевших, из к-рых 955 (60,6%) умерли. В России с 1818 по 1913 г. сообщено о 609 больных Б., около половины к-рых умерли. С улучшением статистического учёта заболеваемости в нашей стране с 1920 по 1939 г. было известно о 674 больных Б., из к-рых более четвертой части умерли. В Японии с 1951 по 1964 г. зарегистрировано 297 больных Б., из к-рых 78 умерли. Во Франции до оккупации фашистскими войсками зарегистрировано 24 заболевших Б.; за время оккупации количество заболевших превысило 1 тыс. чел., что, как оказалось, было связано с употреблением в пищу мяса свиней, забитых тайно в антисанитарных условиях . Этиология. Возбудитель ботулизма Clostridium botulinum (син. Bacillus botulinus) был описан в 1896 г. Ван-Эрменгемом (Е. van Ermengem) во время расследования вспышки Б. в Германии. Изучение этиологии Б. в последующие годы показало, что заболевание вызывается несколькими возбудителями, относящимися к одному виду. Известно шесть типов возбудителей ботулизма: А, В, С, D, E, F. Деление на типы связано с оригинальной антигенной структурой экзотоксина, продуцируемого клеткой. Токсин каждого типа может быть полностью нейтрализован только сывороткой гомологичного типа. Возбудители Б. широко распространены в природе. Местом постоянного обитания спор этих бактерий является почва, откуда они попадают в воду, на фрукты и овощи, в пищевые продукты, фураж, а затем в кишечник человека и животных (млекопитающих, птиц, рыб, беспозвоночных). Берк (G. Burker 1919) при исследованиях в Калифорнии выделила 235 культур из воды, сена, садовой почвы, насекомых, пауков, улиток, лошадиного навоза, кишечного содержимого птиц. Во всех перечисленных выше объектах возбудители Б. образуют споры, устойчивые к воздействию хим. и физ. факторов. Вегетативные формы возбудителей Б. погибают при кипячении в течение 2—5 мин., споровые формы нек-рых штаммов, особенно типов А, В, С, F, высоко терморезистентны. Они выдерживают 1 — 5-часовое кипячение и погибают только при автоклавировании. Ботулинический токсин частично разрушается при нагревании до t 70—90°, при кипячении в течение 5—15 мин. разрушается полностью. В нашей стране в окружающей среде чаще всего встречаются типы А, В, Е, реже типы С и F, при заболеваниях у человека обнаружены типы A, В, Е, у животных — типы А, B, С, Е. Все шесть типов CI. botulinum очень близки по своим морфологическим, культуральным свойствам и по действию их токсинов на организм человека и животных. Они дают одинаковую клиническую картину болезни. Возбудители Б. — строгие анаэробы обычно размножаются и образуют токсин внутри больших кусков рыбы, ветчины, колбасы, в закрытых консервах либо на питательных средах в специальных аппаратах — анаэростатах. На жидких питательных средах рост бактерий сопровождается помутнением среды и газообразованием, возникает запах прогорклого масла, но эти признаки непостоянны. Самым характерным свойством всех типов возбудителей Б. является их способность вырабатывать в анаэробных условиях токсины (см.). Сила токсинов на искусственных питательных средах, в различных консервированных пищевых продуктах может составлять для типа А и В от 10 тыс. до 1—3 млн. в 1 мл смертельных доз для белой мыши. Получены сухие и кристаллические ботулинические токсины, к-рые содержат в 1 мг до 100 млн. смертельных доз для мыши. |
 |
 |
 |
Рис. 1. | ||
 |
 |
 |
Рис. 2. | ||
 |
 |
 |
Рис. 3. | ||
 |
 | |
Рис. 4. | ||
Возбудители Б. типа Е, а также непротеолитические штаммы типа В и нек-рые штаммы типа F образуют на питательных средах и, возможно, в пищевых продуктах недостаточно активный предшественник токсина — протоксин, к-рый значительно усиливает свою биологическую активность при попадании в жел.-киш. тракт человека и животных в результате воздействия протеолитических ферментов. При добавлении трипсина, панкреатина in vitro также происходит активация протоксина, к-рый переходит в токсин.
По морфологии возбудители Б.— небольшие палочки длиной 4—9 мкм и шириной 0,6—0,9 мкм с закруглёнными концами (рис. 1). Палочки образуют субтерминальные или терминальные споры и имеют вид теннисной ракетки (рис. 2 и 3). Эти микробы легко окрашиваются различными анилиновыми красками. Молодые клетки окрашиваются по Граму положительно. Через 4—5 сут. роста палочки окрашиваются грамотрицательно. Микробы подвижны, имеют от 4 до 35 жгутиков (рис. 4), капсулы не образуют.
В посевах в высокий столбик агара микробы образуют колонии, имеющие форму чечевицы (рис. 5) и комочков ваты (рис. 6). При посеве на поверхность кровяного, печёночного или сахарного агара вырастают прозрачные колонии величиной в несколько миллиметров с ровными (рис. 7) или изрезанными (рис. 8) краями и блестящей поверхностью. На кровяном агаре колонии окружены зоной гемолиза (рис. 9).
Оптимальной температурой для роста бактерий типов А, В, С, D является 34—35°, для типов Е и F — температура 26—30°. См. также Clostridium.
 |
 |
 |
Рис. 5. | ||
 |
 |
 |
Рис. 6. | ||
 |
 |
 |
Рис. 7. | ||
Эпидемиология. Своеобразие эпидемиологии Б. определяется тем, что он не передаётся от больного человека здоровому. Основным резервуаром инфекции при Б. являются теплокровные животные (преимущественно травоядные), реже рыбы, ракообразные, моллюски, в кишечнике к-рых накапливаются Gl. botulinum, выделяющиеся с испражнениями в окружающую среду, где переходят в споровое состояние. Последующее прорастание спор на органических субстратах в анаэробных условиях, особенно в диапазоне температуры 22—37°, сопровождается и накоплением микробов и их токсинов. Распространённость заболеваний странах мира определяется: обсеменённостью спорами CI. botulinum объектов окружающей среды, степенью чувствительности человека к токсину данного типа, а также и характером производства (приготовления) пищевых продуктов и особенностями питания и быта населения. Отсутствие в объектах окружающей среды спор CI. botulinuni, естественно, исключает возможность их попадая в пищевые продукты, а современная технология производства к даже при наличии спор предотвращает сохранение или накопление ботулинического токсина при ранении продуктов.
Степень чувствительности человека к ботулиническим токсинам типов А, В, С, D, Е и F неравнозначна. Это подтверждают эпидемиологически данные, касающиеся распространения заболеваний и обсеменённости объектов окружающей среды спорами, а также сведения о различной чувствительности экспериментальна и с.-х. животных к разным типам токсинов.
Споры CI. botulinum имеют широкое распространение. По В. М. Вершу (1941), «источником ботулизма является вся природа», что подчёркивает широкую обсеменённость объектов окружающей среды спорами возбудителя. Однако статистика находок спор незначительна. Это объясняется ограниченными и направленными поисками, связанными с возникшими заболеваниями либо с необходимостью обследования отдельных территорий, откуда поставляются овощи и рыбные продукты для пищевой промышленности.
Совершенствование методов лабораторных исследований в направлении выявления особенностей метаболизма возбудителя и широкое использование типоспецифических сывороток позволили более достоверно установить обсеменённость окружающей среды различными типами С1. botulinum и представить современную географию их распространения.
При исследовании различных проб, в южных в районах Северного Кавказа, Азовского и Каспийского морей, Приморского края, Дальнего Востока, Ленинграда, споры возбудители Б. были обнаружены в 9% проб почвы и 4% проб воды. При этом в пробах почвы обнаружены споры возбудителей типов А, В, С и Е, а в пробах воды и ила тип Е. Среди положительных находок тип Е составлял ок. 74%; он встречался в почве берегов водоёмов практически всех обследованных районов, второе место по частоте находок занимает тип В (16,5%), третье — тип А (7,8%) и четвёртое — тип С (1,8%). В 33% исследованных проб почвы берегов оз. Балхаш и нек-рых районов Армянской ССР также обнаружены споры возбудителя Б.
 |
 |
 |
Рис. 8. | ||
По данным зарубежных исследований, наиболее частые находки спор возбудителя Б. имеют место при исследовании бобов (32%), разлагающихся растений (20%) и перебродивших зелёных кормов (20%).
При анализе заболеваемости Б. обращает на себя внимание то обстоятельство, что все заболевания обусловлены тремя типами токсинов — А, В и Е с преобладанием одного из них в каждой отдельной стране. Так, в США чаще других причиной Б. является тип А, во Франции и Норвегии — тип В, в Японии практически все заболевания связаны с типом Е, в Канаде преобладает тип Е. В нашей стране. Заболевания обусловливаются тремя типами токсина (А, В и Е). Заболевания, вызванные токсинами типа С, D и F, встречаются крайне редко. Описан один случай группового отравления (оз. Чад), вызванного токсином типа D. Описаны также единичные случаи отравления токсином типа С. Что касается возбудителя, продуцирующего токсин типа F, недавно обнаруженного в СССР, то заболевания, связанные с ним, зарегистрированы только в Дании и США по одному разу.
 |
|
 |
Рис. 9. | ||
Т. о., неравнозначность в патологии ботулинических токсинов различных типов очевидна. Она обусловлена не столько вероятностью попадания в организм человека токсина какого-либо типа, сколько естественной резистентностью человека к одним и высокой чувствительностью к другим типам токсинов, хотя существует мнение (К. И. Матвеев, 1959), что все теплокровные животные, вт. ч. и человек, в равной степени чувствительны к ботулиническим токсинам всех типов. Однако известно, что степень чувствительности теплокровных животных неодинакова. Высокорезистентными к ботулиническим токсинам являются свиньи, собаки, волки, лисы, дикие и домашние кошки, львы, тигры, а также многие птицы. Эти виды являются «санитарами», уничтожающими больных животных и падаль, и характер их питания представляет исключительные возможности контактов с возбудителями Б. и их токсинами. Наиболее чувствительными к ботулиническим токсинам являются лошади, характер питания к-рых исключает широту таких контактов, и многие лабораторные животные. Это биологическое явление, заключающееся в различной чувствительности теплокровных животных к представителям одной группы токсинов, находит объяснение в эволюционном развитии видов и их взаимоотношении с возбудителями Б. В процессе этой эволюции определенная часть особей вида, обладавших индивидуальной (но генотипически обусловленной) способностью в большей степени противостоять патогенному действию токсинов, выживала, передавая эти особенности следующим поколениям. Надо полагать, что и далёкие предки человека, употреблявшие сырое и гниющее мясо, имели также самые широкие контакты с возбудителями Б., и прежде всего с типами С и D как с наиболее древними представителями клостридиозов.
Патологическая анатомия. Патологоанатомические изменения, обнаруживаемые при вскрытии трупа больного, погибшего от Б., не представляют собой чего-либо специфического. Как правило, обнаруживается резкая гиперемия всех висцеральных органов, сопровождающаяся множественными мелкими и крупными кровоизлияниями. Оболочки головного мозга сильно гиперемированы, встречаются геморрагии. В ткани мозга обнаруживаются тромбозы, поражения эпителия сосудов некротического и деструктивного характера. Стенки сосудов ткани мозга разрыхлены. Наиболее поражены ганглиозные клетки нервной системы. Наблюдается вакуолизация протоплазмы, распад ядра. Форма клеток изменяется, отростки отпадают, изменения происходят также в нейроглии.
В сердце волокна соединительной ткани набухают, наблюдаются явления некробиоза. Происходит фрагментация миокарда; полосатая исчерченность исчезает. Сосуды резко переполняются кровью, обнаруживается набухание эндотелия в капиллярах и мелких сосудах.
Легкие наполнены кровью, отёчны. Наблюдается картина резкой геморрагической пневмонии; в нек-рых случаях имеется опеченение отдельных участков лёгкого, а иногда и целых долей. Капилляры лёгкого резко расширены, в альвеолах скопление эритроцитов. Печень полна кровью, увеличена, буроватого цвета, дряблой консистенции. При микроскопии отмечается зернистое перерождение клеток печёночной ткани, жировая альтерация, набухание коллагеновых волокон соединительной ткани, диссоциация печёночной паренхимы.
В почках сильно изменён эпителий извитых канальцев, в прямых канальцах дистрофические изменения.
Слизистая оболочка пищеварительного тракта резко гиперемирована. Слизистая оболочка желудка набухшая, желтоватого цвета, разрыхлена, очень легко разрывается, в ней видны точечные и более крупные кровоизлияния. Сосуды кишечника резко инъецированы и придают серозной оболочке мраморный рисунок; слизистая оболочка кишечника набухшая, при микроскопии обнаруживается расширение сосудов, повреждение стенки и выход эритроцитов.
Из скелетных мышц сильнее всего поражается мускулатура грудной клетки, брюшной стенки и конечностей. Мышцы имеют «варёный», с сероватым оттенком вид; при микроскопии обнаруживается расширение сосудов, стаз в капиллярах, исчезает поперечнополосатая исчерченность, волокна набухают, имеют вид как при ценкеровском перерождении.
Патогенез. Основным патогенетическим фактором при Б. является ботулинический токсин. По мнению ряда исследователей, патогенез Б. носит токсический характер. Следует отметить важную особенность, касающуюся генеза интоксикации токсином типа Е. На питательных субстратах этот тип возбудителя Б. образует токсин меньшей силы , чем возбудители типов А, В и F, однако тяжесть интоксикации и летальность при Б. типа Е превосходит, как правило, таковые при Б. типов
А, В и F. Причиной таких различий является существование токсина Е в двух формах: протоксина и токсина.
Малоактивный протоксин, попадая с пищевыми продуктами в желудок, активизируется ферментами, превращается в токсин и уже в активном состоянии всасывается в кишечнике. Поэтому освобождение желудка от содержимого как важное лечебное мероприятие при ботулинической интоксикации, обусловленной токсином типа Е, приобретает исключительное значение.
Кроме пищеварительного тракта, токсин может проникнуть и через дыхательные пути при вдыхании пыли, его содержащей. Известны также случаи раневого Б., когда споры CI. Botulinum попадали в рану с почвой, там прорастали, вызывая болезнь, а также случай заболевания, связанный с переливанием трупной крови, взятой у погибшего от Б. (заболевание у погибшего не было распознано).
CI. botulinum выделяются из организма с фекалиями, токсины — с мочой, желчью и фекалиями.
В эксперименте при ботулинической интоксикации установлены две важные закономерности: первая состоит в том, что одномоментное введение различных типов токсина приводит в итоге к суммации токсического действия; вторая закономерность связана с феноменом парадоксальной чувствительности, когда многократное и частое введение токсина приводит к летальному исходу, хотя общая доза его не превышала половины смертельной дозы. Установлено, что ботулинический токсин типа А избирательно действует на периферические холинергические нервные окончания, в то время как адренергические ткани нечувствительны к нему.
Из крови токсин проникает в органы, где поражает клетки различных тканей, в первую очередь нервной системы, наиболее чувствительной к ботулиническим токсинам. Ботулинический яд действует на мотонейроны спинальных моторных центров и продолговатого мозга, что является причиной развития паралитического синдрома, а также на периферические моторные нервно-мышечные приборы, вызывая нарушение передачи возбуждения с нерва на мышцу. При этом нет полной блокады передачи импульсов. Кроме этого, ботулинический токсин в очень больших дозах угнетает тканевое дыхание головного мозга, но эти изменения не являются причиной смерти. Клинические наблюдения и экспериментальные данные позволяют считать ботулинический токсин и сосудистым ядом, в основе действия к-рого лежит поражение нервной системы сердца и сосудов. Кратковременная перфузия токсина через сосуды вызывает m спазм, длительное воздействие приводит к парезу сосудов и ломкости капилляров.
Молекулярные механизмы взаимодействия токсинов и клетки остаются нерасшифрованными.
Иммунитет. Перенесённое заболевание не оставляет иммунитета. Имеются сообщения о повторных заболеваниях. Так, К. М. Аянян (1967) наблюдал Б. у двух детей в 1963 г, и повторно у них же через год. Оба ребёнка погибли. Как в первый, так и во второй раз был установлен токсин CI. botulinum типа А.
Клиническая картина. Инкубационный период 12—24 часа, но может удлиняться до 10 дней. Чем короче инкубационный период, тем тяжелее течение болезни. Во время вспышки наблюдаются случаи заболевания как с коротким, так и с более длительным инкубационным периодом даже в том случае, если лица ели одновременно один и тот же продукт. Это, видимо, объясняется неравномерным распределением токсина в пищевом продукте, а также индивидуальной чувствительностью заболевших.
В подавляющем большинстве случаев Б. начинается остро. Симптомы чаще могут проявляться в виде трёх основных вариантов: с преобладанием диспептических расстройся, расстройств зрения или дыхательной функции. При первом варианте заболевание начинается с чувства тошноты, быстро присоединяется рвота, к-рая может быть только в начальном периоде болезни. Отдельные больные отмечают схваткообразные, иногда интенсивные пот в эпигастральной области. Часто отмечается чувство переполнении и распирания желудка. Одновременно развивается сухость слизистых покровов ротовой полости, и больной ощущают сильную жажду. Характерны выраженный метеоризм, запоры, к-рые в результате пареза кишечника могут быть очень стойкими, Однако в начальном периоде болезни нередко наблюдается послабление стула, при этом каловые массы не содержат патологических примесей.
К ранним признакам Б. отнесены и симптомы расстройства глотания, к-рые в ряде случаев развиваются уже в первые часы болезни. Больные жалуются на наличие «комка» и горле, болезненность при глотании, чувство «царапанья» за грудиной, несколько позже присоединяется поперхивание.
Если болезнь начинается с расстройств зрения, то больные нередко обращаются к окулисту. Первоначально они жалуются на «туман», «сетку», «мушки» перед глазами. Чтение обычного шрифта затруднено или невозможно (парез аккомодации), реже наблюдается двоение предметов.
У отдельных больных развивается «острая дальнозоркость», к-рая может быть корригирована соответствующими линзами. Расстройства зрения в начальном периоде Б. часто протекают без диспептических симптомов, что затрудняет диагноз. При тщательном обследовании больного, помимо разнообразных расстройств зрения, можно установить наличие сухости во рту, жажду, изменение тембра голоса (осиплость, «грубый» голос), а также симптомы общей интоксикации: головную боль, головокружение, общую мышечную слабость, быструю утомляемость, бессонницу. Все эти симптомы в начальном периоде не всегда достаточно чётко выражены или могут быть пропущены при осмотре в связи с резким преобладанием глазной симптоматики. Если диспептический вариант начальных проявлений Б. продолжается несколько часов, то расстройства зрения без других характерных проявлений болезни могут сохраняться В течение нескольких дней.
Наиболее тяжёлое течение Б. бывает при начальном развитии дыхательных расстройств. Больные среди полного здоровья начинают ощущать нехватку воздуха, делать неожиданные паузы во время разговора. Иногда эти паузы возникают между отдельными слогами. Появляется чувство стеснения или тяжести и груди, в отдельных случаях возникают боли в грудной клетке. Дыхание обычно не учащено, но поверхностное. Одновременно с расстройствами дыхания изменяется голос, который становится не только сиплым, но и приобретает носовой оттенок. К дыхательным расстройствам быстро присоединяется нарушение акта глотания. Всегда выражены симптомы общей интоксикации: головная боль, резкая мышечная слабость, головокружение и др.
Вслед за начальными проявлениями Б. болезнь вступает в фазу наивысшего развития симптоматики. Субъективно больные отмечают «туман», «сетку», «мелькание» или «мушки» перед глазами. Контуры предметов становятся расплывчатыми. При попытке чтения буквы и строчки «разбегаются». Эти симптомы развиваются вследствие влияния на ресничную мышцу токсина, приводящего к её расслаблению, что ведёт к параличу аккомодации. Часто наблюдается двоение предметов, особенно при повороте глазных яблок в стороны. В тяжёлых случаях наблюдается паралич одного или нескольких черепных нервов, иннервирующих мышцы глаза, офтальмоплегия (см.).
Почти всегда отмечается выраженное и стойкое расширение зрачков — мидриаз. Этот симптом появляется одним из первых и наиболее длительно сохраняется. Нередко наблюдается неравенство зрачков— анизокория (см.). Реакция зрачков на свет резко снижена или вообще отсутствует. Иногда больные не в состоянии различать очертания предметов и воспринимают только световые раздражения. Часто наблюдается птоз (см.), нередко двусторонний, однако степень опущения верхнего века может преобладать на какой-либо одной стороне. При более тяжёлом течении Б. глаза могут быть полностью закрыты, и для того чтобы раскрыть их, больные вынуждены руками приподнимать верхнее веко.
Действие ботулинического токсина распространяется на глазодвигательный и отводящий нервы, происходит нарушение движения глазных яблок, возникает ощущение двоения предметов. Обычно раньше появляется парез латеральной прямой мышцы глаза, что ведёт к сходящемуся косоглазию. В редких случаях, когда преобладает парез глазодвигательного нерва, имеет место расходящийся стробизм. При тяжёлом течении Б. наблюдается одновременное стойкое поражение всех глазодвигательных мышц, что приводит к полной неподвижности глазных яблок. У ряда больных можно установить наличие нистагма, чаще вертикального.
Расстройства глотания являются характерными симптомами, но встречаются реже, чем глазная симптоматика. Больные вначале жалуются на затруднение и болезненность при глотании. В дальнейшем они ощущают чувство «комка» в горле, и, наконец, нарушается акт глотания. Присоединившееся расстройство движения языка ухудшает акт глотания, изменяет артикуляцию. В тяжёлых случаях Б. больной не в состоянии передвинуть кончик языка через край зубов. Развивающийся парез надгортанника ведёт к неполному закрытию дыхательных путей при глотании, что создаёт возможность попадания пищи в дыхательные пути, вызывая поперхивание, приступы кашля и удушья.
У больных с расстройством акта глотания наблюдается отсутствие глоточного рефлекса, можно отметить явления пареза мягкого неба. В тяжёлых случаях нёбная занавеска неподвижна, свисает на корень языка. При попытке проглотить воду она вытекает через нос.
В первые часы болезни отмечается снижение тембра голоса и осиплость, что связано со снижением саливации и сухостью голосовых связок. По мере развития парезов к этим симптомам присоединяются нечёткая артикуляция («комки во рту») и гнусавость, а с развитием пареза голосовых связок может наступить полная афония.
Реже у больных Б. отмечаются вялые парезы лицевой мускулатуры вследствие поражения VII пары черепных нервов. С первых часов у больных развивается резкая миастения, к-рая беспокоит больного на протяжении всего периода интоксикации. Вместе с тем при Б. никогда не бывает поражения чувствительной сферы, а также потери сознания.
При тяжёлом течении Б. характерно развитие парезов дыхательной мускулатуры, что выражается в отсутствии диафрагмального дыхания, резком ограничении подвижности межрёберных мышц, исчезновении кашлевого рефлекса. Расстройство и остановка дыхания являются одной из основных причин смерти при Б. Дыхательная недостаточность принимает особенно тяжёлое течение ещё и потому, что наряду с парезами дыхательных мышц у больных, как правило, обнаруживаются воспалительные процессы в лёгких. В начале болезни больные отмечают «нехватку» воздуха, чувство стеснения и тяжести в груди, быстро устают во время разговора или делают неожиданные паузы, чтобы глубоко вздохнуть. Частота дыхания может достигать 30—40 в 1 мин., в дальнейшем отмечаются патологические виды дыхания.
Сердечно-сосудистая система страдает вторично, на почве интоксикации, при более тяжёлом течении болезни (тахикардия, приглушение сердечных тонов, иногда расширение границ относительной тупости сердца, систолический шум у его верхушки, признаки дистрофии миокарда по данным электрокардиографии). Артериальное давление, как систолическое, так и диастолическое, имеет нек-рую тенденцию к повышению, что связывают с сосудосуживающим действием токсина.
При Б. температура тела не повышается, но при тяжёлых формах болезни возможна гипертермия как в начальных стадиях, так и в более позднем периоде. Однако повышение температуры тела у больных Б. в позднем периоде болезни чаще обусловлено присоединением пневмонии.
У части больных отмечается олигурия, снижение удельного веса мочи, альбуминурия. В осадке гиалиновые и зернистые цилиндры, эритроциты. Уровень остаточного азота крови может превышать нормальные значения.
В крови чаще отмечается умеренный (иногда и значительный) лейкоцитоз с нейтрофилезом и появлением юных форм нейтрофилов (при тяжёлых формах болезни).
Осложнения. При нарушениях глотания — аспирационные пневмонии. У выздоравливающих могут наблюдаться миозиты, сопровождающиеся болями и затруднениями движений, и инфекционный миокардит. Возможно развитие миопии.
Диагноз ставится на основании данных анамнеза, клинических и лабораторных исследований.
Лабораторная диагностика основывается на обнаружении ботулинического токсина или возбудителя Б. в материалах, взятых от больного (кровь, рвотные массы, промывные воды желудка, кал и др.), а также в пищевых продуктах, к-рые вызвали отравление. Важно установить не только присутствие токсина или микроба, но и определить его тип, чтобы подтвердить клинический диагноз и назначить правильное лечение.
Кровь необходимо брать до введения больному леч. сыворотки. В пробы, взятые для лабораторных исследований, а также в пищевые продукты, нельзя добавлять консервирующие вещества. Материалы должны храниться в холодильнике.
Пробы, поступившие в лабораторию, исследуются одновременно по двум направлениям: две трети предварительно подготовленной пробы (получают фильтрат или центрифугат) предназначаются для обнаружения ботулинических токсинов в реакции нейтрализации, одна треть — для посевов с целью выделения ботулинических микробов.
Для обнаружения токсина для каждой пробы берут 4 мышей весом 16—18 г. В связи с тем что в исследуемом материале может быть один из шести типов ботулинических токсинов, предварительную реакцию необходимо ставить со смесью противоботулинических диагностических сывороток всех типов. Нельзя пользоваться для целей диагностики лечебными противоботулиническими сыворотками. Из каждой исследуемой пробы наливают в две пробирки равное количество (по 1,5—2,4 мл) фильтрата или центрифугата. В одну (первую) пробирку (контроль) добавляют 0,6 мл физиологического раствора, в другую (опыт)—0,6 мл смеси моновалентных сывороток, после чего содержимое первой пробирки вводят двум белым мышам внутрибрюшинно или в вену в объеме 0,7—1,0 мл, тот же объем второй пробирки (опыт) вводят второй паре белых мышей. Исследуемый материал из каждой пробирки следует вводить разными шприцами.
Наблюдение за животными ведётся в течение 4 дней, однако если мыши болеют или погибают раньше этого срока, то тут же ставится реакция нейтрализации с моновалентными диагностическими сыворотками.
 |
 |
 |
Рис. 10. | ||
При наличии в пробе ботулинического токсина погибают две мыши, к-рым вводился фильтрат без сывороток, остальные две остаются живы. Обычно картина болезни и гибели мышей очень характерна: появляется учащённое дыхание, состояние полного расслабления мышц, западение мышц брюшной стенки («осиная талия» — рис. 10), параличи и судороги перед смертью.
В случае гибели всех 4 мышей следует повторить реакцию нейтрализации с экстрактами, разведёнными в 5, 10, 20, 100 раз. При разведении экстрактов посторонняя микрофлора теряет способность убивать мышей, а ботулинический токсин, обладая обычно большей биологической активностью, будет вызывать гибель мышей при разведении фильтратов.
В случае обнаружения в реакции с поливалентной сывороткой ботулинического токсина сразу же ставится развёрнутая реакция нейтрализации для определения типа токсина с типоспецифическими диагностическими сыворотками.
Особое внимание нужно обратить на постановку реакции нейтрализации с сывороткой крови больного, т. к. её обычно бывает мало. Следует тщательно отделить сыворотку от сгустка крови и сразу поставить развёрнутую реакцию нейтрализации с моновалентными ботулиническими сыворотками типов А, В, Е (остальные типы Б. встречаются очень редко).
При получении положительной реакции нейтрализации с диагностическими ботулиническими сыворотками даётся заключение о наличии в исследуемом материале ботулинического токсина и указывается его тип.
Нередко постановку реакции нейтрализации как с поливалентной, так и с моновалентными сыворотками приходится повторять из-за неспецифической токсичности посторонней микрофлоры, к-рая обычно имеется в рвотных массах, кале, поэтому в лучшем случае ответ о наличии токсина в пробе может быть дан на 2—3-й день, а о его типовой принадлежности — на 3—5-й день от начала исследования.
В случае невозможности обнаружения токсина в исследуемых материалах проводятся исследования по обнаружению возбудителя Б.
С этой целью производится посев 3—5 мл подготовленного материала на жидкие питательные среды. Для первичных посевов лучше использовать казеиново-грибную или казеиново-кислотную среду, бульон Хоттингера или среду типа Тароцци. Необходимо, чтобы рН был в пределах 7,2—7,4. Обязательным является также наличие в мясных средах мясного или печеночного фарша, а в казеиновых — отварною пшена и ваты. Пробирка или флакон должны быть заполнены питательной средой не менее чем наполовину. Перед посевом в среды добавляют 0,5% глюкозы.
Посевы должны производиться в среды в больших пробирках или во флаконах ёмкостью по 100 - 200 мл. Сверху среда заливается слоем вазелинового масла толщиной в 0,5 см. Следует особенно помнить о том, что лучше засевать исходный посевной материал в большой объем среды (70—150 мл), чтобы культуральной жидкости первичного посева хватило на все исследования, Последующие пересевы исследуемых проб из первичного посева в теже жидкие питательные среды могут не дать токсинообразования в среде, Посев следует производить в четыре флакона, два из к-рых прогревают при t° 80° 20 мин. Два других флакона после посева не прогревают. Все флаконы помещают в термостат при t° 28 и 35° (в каждый термостат один прогретый, один непрогретый).
Если в исследуемом материале возбудители Б. находятся преимущественно в вегетативной форме, то рост в посевах будет гл. обр. в непрогретых флаконах. В том же случае, если в материале имеются споровые формы, рост будет в прогретых флаконах и в отдельных случаях может сразу привести к выделению чистой культуры из такого посева.
Через 48 час. от начала роста из всех флаконов с соблюдением стерильности берут пробы культуральной жидкости (по 10—15 мл) и подвергают их исследованию. С культуральной жидкостью ставится реакция нейтрализации с поливалентной противоботулинической сывороткой. При получении положительных результатов реакцию нейтрализации ставят с каждой типоспецифической сывороткой раздельно. Если через двое суток во флаконах не обнаружен рост, то необходимо продолжать инкубацию в термостате, а исследование провести на 4-6—10-е сут. При обнаружении в исследуемом посеве палочек, типичных по морфологии для CI. botulinum, а также ботулинического токсина даётся заключение о заражённости исследуемого материала возбудителем Б. Выделение чистой культуры в таком случае не является обязательным.
Если в посевах обнаруживаются микробы, по морфологии сходные с CI. botulinum, а токсин отсутствует, следует провести активацию культуральной жидкости панкреатином или трипсином.
Решающим для ответа о заражённости исследуемого материала возбудителем Б. и его типе являются новые реакции нейтрализации. В сомнительных случаях производят выделение (с высокого столбика агара, с посевов на чашки Петри) чистой культуры. Отдельные колонии, характерные по морфологии щ CI. botulinum, высевают на жидкие среды и исследуют через 3-5 сут. роста в реакции нейтрализации с типоспецифическими противоботулиническими сыворотками.
Реакция нейтрализации является достоверным, высокоспецифичным и достаточно чувствительным методом обнаружения ботулинических токсинов.
Другие предложенные методы лабораторной диагностики Б. (реакция пассивной гемагглютинации, метод подсчёта фагоцитарного индекса, люминесцирующие сыворотки) являются сугубо экспериментальными и в широкой практике не применяются из-за недостаточной специфичности.
Дифференциальный диагноз. Б. следует дифференцировать с отравлением беленой. В отличие от Б., первые признаки отравления наступают через 1—5 час. после употребления в пищу растения. Отмечается разбитость, сонливость, головокружение, головная боль. Может быть тошнота, редко рвота. Кожные покровы лица и туловища гиперемированы, иногда обнаруживается скарлатиноподобная сыпь. Сходство с Б. заключается в стойком расширении зрачков и отсутствии реакции их на свет, сухости слизистых оболочек рта, нарушении саливации. Закономерно наблюдаются расстройства психики. Больные обычно очень беспокойны, двмжения их не координированы, наблюдается неадекватная реакция на окружающие явления, бред, чаще значительными галлюцинациями. Могут возникать клоникотонические судороги. Отмечается тахикардия, нарушение ритма, снижение артериального давления, глухость сердечных тонов. При развитии комы наблюдается резкая бледность кожных покровов, брадикардия, одышка, расстройство ритма дыхания. Смерть наступает от остановки дыхания.
Отравление метиловым спиртом также ведет к развитию ряда симптомов, сходных с Б. Отмечается общая слабость, звон в ушах, тошнота, рвота, иногда боли в животе. Зрачки расширены и плохо реагируют на свет. Нарушения зрения носят двухволновый характер. Сначала больные отмечают мелькания перед глазами, снижение остроты зрения, «туман», двоение предметов; затем может наступить нек-рое улучшение зрения, после чего развивается слепота, что не наблюдается при Б. В тяжёлых случаях отравления отмечаются галлюцинации, страх, судороги, ослабление мышечной силы, потеря сознания, падение сердечно-сосудистой деятельности, но парезы не наблюдаются.
При дифференциальной диагностике с отравлением ядовитыми грибами нужно учитывать, что Б. обычно возникает при употреблении в пищу консервированных грибов, в то время как отравление ядовитыми грибами происходит чаще при употреблении свежеприготовленных грибов.
При отравлении мухомором, связанном прежде всего с действием мускарина, обладающего атропиноподобным действием, мускаридина и пильцтоксина, отмечается сильное слюнотечение, потоотделение, профузный понос, коликообразные боли в животе, замедление пульса, побледнение лица, стойкое расширение зрачков (последнее напоминает Б.). В более тяжёлых случаях отмечаются галлюцинации (чаще зрительные), покраснение кожных покровов лица и судороги.
Раннее наступление дыхательных расстройств у ряда больных полиомиелитом тоже может быть ошибочно расценено как Б. В отличие от Б., при полиомиелите имеет место обильное слизеотделение и саливация.
Для дифференциального диагноза с дифтерией имеют значение изменения в зеве — дифтеритические налеты. Неврологические расстройства при дифтерии обычно возникают после ангины, повышения температуры тела, отёчности подкожной клетчатки. Параличи чаще наступают одновременно с развитием миокардита.
Прогноз при Б. всегда тяжёлый. Активной и только ранней серотерапией и применением искусственного аппаратного дыхания удаётся спасти жизнь даже тем больным, к-рые ранее являлись обречёнными. Выздоровление происходит медленно, обычно в течение месяца и более. Работоспособность восстанавливается ещё более длительно; миопия, возникшая в остром периоде заболевания, сохраняется также долго.
Лечение. Больные подлежат безусловной госпитализации. Необходимо срочно провести промывание желудка и очистить кишечник. Следует учитывать, что промывание желудка при Б. достаточно сложно, т. к. в связи с отсутствием у больного глоточного рефлекса и наличием пареза надгортанника возможно попадание зонда в дыхательные пути. Перед промыванием необходимо точно убедиться, что зонд находится в желудке.
С целью нейтрализации свободно циркулирующего в крови ботулинического токсина необходимо применение противоботулинических сывороток. Наиболее эффективно их введение в первые дни болезни, т. к. наивысшая концентрация токсина в крови наблюдается на 2—3-й сут. болезни (Л. М. Шведов, 1960).
Однако, учитывая возможность длительного поступления токсина в кровь больного, можно считать, что леч. эффект от сывороточной терапии будет выражен и в более поздние сроки болезни. В случаях, когда ещё неизвестен тип токсина, вызвавшего заболевание, необходимо введение всех четырёх типов сыворотки (А, В, С, Е). После установления типа возбудителя вводят сыворотку соответствующего типа. Нужно учитывать, что возможно отравление несколькими типами токсина. Сыворотку можно вводить как внутривенно, так и внутримышечно. Первоначально вводится сыворотка типа А —10 000 ME, типа В—5000 ME, типа С — 10000 ME, типа Е—10 000 ME. Однако нередко этого количества бывает недостаточно для полной нейтрализации токсина. Возможны последующие введения сыворотки, дозы к-рой будут зависеть от клинического эффекта. Обычно для лечения тяжёлых форм Б. на полный курс лечения расходуется по 50 000—60 000 ME типов А, С, Е и 25 000— 30 000 ME типа В. Однако и эти дозы могут быть увеличены.
В общий комплекс лечения больных Б. входит неспецифическая дезинтоксикационная терапия, к-рая складывается из введения солевых растворов, глюкозы и кровезаменителей. Особенно благоприятным воздействием обладают низкомолекулярные растворы — гемодез, поливинилпирролидон, а также плазма крови.
Учитывая возможность вегетации возбудителя из спор в жел.-киш. тракте больного, многие клиницисты рекомендуют применение левомицетина или препаратов тетрациклинового ряда. Продолжительность лечения 7—8 дней. С применением антибиотиков сократилась частота «обострений» заболевания.
С целью сокращения сроков восстановления нарушений со стороны нервной системы показано назначение АТФ в виде 1% раствора по 2 мл три раза в день в течение 7 — 10 дней.
Поражение сердечнососудистой системы требует применения камфоры, кордиамина, сердечных гликозидов.
Больной должен получать леч. дозы витаминов, прежде всего из групп С и В.
Особое место в лечении больных занимают вопросы борьбы с расстройствами дыхания. Оправдано применение искусственного аппаратного дыхания. Дыхательная реанимация при Б. складывается из устранения закупорки дыхательных путей и создания адекватной лёгочной вентиляции с помощью респираторов.
Показаниями для наложения трахеостомы и эндотрахеальной искусственной вентиляции при Б. являются парезы мышц глотки, гортани и языка с жалобами на затруднённое дыхание, парезы дыхательных мышц со снижением жизненной ёмкости лёгких до 30%, ослабление кашлевого рефлекса, ателектазы и воспалительные процессы в лёгких. Рекомендуется применять аппараты, регулирующиеся по объёму с независимой частотой дыхания.
Несмотря на уменьшение саливации, больному необходимо периодически проводить отсасывание слизи, скапливающейся в верхних дыхательных путях.
При развитии пневмонии больным необходима соответствующая антибиотическая терапия.
В стадии поздней реконвалесценции для лечения парезов с успехом могут применяться физиотерапевтические процедуры.
Профилактика. По мере совершенствования технологии переработки пищевых продуктов при оптимальных температурных режимах Б. среди людей, связанный с использованием для питания продуктов промышленного производства, практически исчезает. Основное место как причина возникновения заболевания во многих странах мира и в СССР занимают различные пищевые продукты домашнего приготовления (консервированные, маринованные, копчёные, вяленые и др.). Однако в США в 1963 г. от коммерческих продуктов заболели Б. 25 чел., 9 из к-рых умерли. В Японии Б. связан с употреблением национального блюда «изуши», составной частью к-рого является сырая рыба, у эскимосов Аляски — блюда из мяса белого кита, у индейцев на побережье Тихого океана Северной Америки — икры лосося. До данным, представляющим исторический интерес, до 1964 г. в США основным источником Б. являлись плохо стерилизованные или маринованные овощи и фрукты, содержащие недостаточный процент кислоты. Во Франции, Дании, Норвегии, Швеции, Югославии и других странах Европы Б. был связан гл. обр. с ветчиной и рыбой домашнего приготовления.
Знание оптимальных условий прорастания спор, их устойчивости к воздействию температуры, а также условий токсинообразования, позволяет чётко определить основные требования к процессам технологической обработки пищевых продуктов, исключающие возможность накопления в них ботулинических токсинов. К таким требованиям относятся: предохранение продуктов от загрязнения спорами возбудителей Б., термическая обработка продуктов, обеспечивающая гибель спор (стерилизация), вегетативных клеток и разрушение токсина, исключение возможности прорастания спор и токсинообразования в готовом продукте.
Необходимость максимального ограждения продуктов от попадания в них спор или обязательное удаление их при очистке и промывании проточной водой (овощи, фрукты, грибы) определяется широким обсеменением объектов внешней среды этим возбудителем. Применительно к мясным и рыбным продуктам освобождение от спор осуществляется аккуратным и быстрым удалением кишечника при послеубойной разделке туш и рыбы, особенно красной, немедленно после улова.
Совершенно обязательным при этом является немедленное охлаждение продуктов после их очистки и промывания, поскольку дальнейшие технологические операции, такие как консервирование, посол, копчение и маринование, не могут разрушить токсин, образовавшийся за время хранения продуктов в тепле, а используемые для консервирования или маринования вещества (поваренная соль, сахар, кислоты) способны лишь задержать дальнейшее токсинообразование.
Правильный температурный режим в процессе обработки продуктов имеет исключительное значение. Обычная тепловая обработка продуктов, предназначенных для непосредственного использования, может быть эффективной только при условии реализации их в первые часы, поскольку, разрушая токсин при обычных условиях нагрева до 100°, она не нарушает жизнеспособности спор. При постепенном охлаждении и продолжительном хранении при комнатной температуре в таких продуктах может накапливаться токсин за счёт проросших в вегетативные клетки спор. Совершенно очевидно, что повторная тепловая обработка таких продуктов перед употреблением является обязательной.
Стерилизация продуктов должна проводиться только в автоклавах, где соответствующее повышении давление позволяет создавать температуру 120°, оказывающую губительное действие не только на вегетативные клетки и их токсины, но и на споры. Такие продукты, выпускаемые промышленностью, безвредны даже в случае длительного хранения при комнатной температуре, Это положение не может распространяться на консервы домашнего приготовления, т. к. температурное воздействие при этом не превышает 100°, а герметизация банок создает оптимальные анаэробные условия для прорастания оставшихся спор, вегетации и токсинообразования в пищевом субстрате. Поэтому в домашних условиях при отсутствии автоклава нельзя консервировать в герметических банках мясные и рыбные продукты, являющиеся хорошей питательной средой. Это положение полностью распространяется на консервирование грибов и овощей, к-рые невозможно абсолютно освободить от спор возбудителя Б, Такие продукты допустимо заготавливать впрок только путём маринования или соления с добавлением достаточного количества кислоты в соли и обязательно в открытой для доступа воздуха таре.
Внешним проявлением зараженности консервов спорами возбудителей Б. и развития их в субстрате консервов является газообразование, приводящее к бомбажу тары (вздутие крышек). При этом консервы размягчаются, структура их изменяется, появляется неприятный запах. Однако описаны случаи, когда ботулинический токсин обнаруживался во внешне не изменённых консервах.
В целях предупреждения заболеваний Б. технологические процессы на пищевых предприятиях, где производятся консервированные продукты, строго регламентированы соответствующими инструкциями, отклонения от к-рых недопустимы.
Применительно к виду сырья или продуктов существуют жёсткие требования, возможности исполнения к-рых определяют готовность данного предприятия к выпуску доброкачественной продукции. Такие требования существуют к производству молочных продуктов, к обработке овощей, фруктов и сырья из зелени, к переработке грибов, к подготовке различных маринадов, пряностей, специй и других веществ, используемых для консервирования. Жёсткие требования предъявляются также к консервным банкам, подготовке их к заполнению и контролю их герметичности. Гарантией выпуска предприятием доброкачественной продукции являются: хорошее сан. состояние оборудования завода, использование для технологических ней свободной от анаэробных микроорганизмов питьевой воды, тщательная мойка сырья и обработка вспомогательных материалов, соблюдение режимов переработки, исключающих развитие в продуктах возбудителя Б., установление регламентированной кислотности продуктов, использование только герметичной тары при постоянном контрою работы закаточных машин, использование режимов стерилизации, адаптирующих полное обезвреживании консервов (разрушение токсина, гибель вегетативных клеток и шор).
Исключительно эффективным срединой специфической профилактики Б. у человека является вакцинация ботулиническим полианатокром. Учитывая экзотичность заболеваемости Б. в СССР это средство не имеет широкого применения и попользуется лишь в случаях защиты персонала лабораторий, проводящих исследования с возбудителем Б.
Ботулизм в судебно-медицинском отношении. Для экспертной диагностики отравления ботулиническим токсином необходимо иметь следственные данные об условиях возникновения отравления (характер продуктов, употреблявшихся в пищу, количество пострадавших, замеченные симптомы, медицинские документы об оказании помощи). Судебно-медицинский эксперт должен иметь в виду характерные особенности клиники отравления. При исследовании трупа специфических для Б. изменений не устанавливается; обычно наблюдается картина быстро наступившей смерти. Обязательно гистологическое исследование, при к-ром выявляется картина расстройства кровообращения, патетическое состояние капилляров и нериваскулярные кровоизлияния и ц. н. с, дегенеративные изменения нервных клеток (гл. обр. в ядрах глазодвигательных нервов, в продолговатом мозге и четверохолмии). Может наблюдаться также еретическое состояние мелких сосудов в стенке тонкой и толстой кишки, в лёгких, миокарде. Кроме того, на суд.-хим. исследование направляют органы (по общим правилам), а на бактериологическое — кровь, пищевые массы, промывные воды, мочу, оставшиеся пищевые продукты.
Окончательный вывод об отравлении ботулиническим токсином суд.-мед. эксперт составляет по совокупности всех полученных данных. См. также Пищевые отравления, Токсикоинфекции пищевые.
|
Булатова Т.И.; Бургасов П.Н.; Дербоглав В.К.; Пак С.Г.; Покровский В.И. |

|
⇐ Перейти на главную страницу сайта |
⇑ Вернуться в начало страницы ⇑ |
Библиотека Ordo Deus ⇒ |
⇐ Бородавка |
⇓ Полный свод знаний. Том первый А. ⇓ |
Боуэна болезнь ⇒ |
|
Все статьи в полном изложении, Вы можете найти в большой медицинской энциклопедии — Главный редактор: академик АН СССР (РАН) и АМН СССР (РАМН) Б.В. Петровский. — Москва издательство «Советская энциклопедия» 1989г. |
|
Внимание! Вы находитесь в библиотеке «Ordo Deus». Все книги в электронном варианте, содержащиеся в библиотеке «Ordo Deus», принадлежат их законным владельцам (авторам, переводчикам, издательствам). Все книги и статьи взяты из открытых источников и размещаются здесь только для чтения. |
|
Библиотека «Ordo Deus» не преследует никакой коммерческой выгоды. |
|
Все авторские права сохраняются за правообладателями. Если Вы являетесь автором данного документа и хотите дополнить его или изменить, уточнить реквизиты автора, опубликовать другие документы или возможно вы не желаете, чтобы какой-то из ваших материалов находился в библиотеке, пожалуйста, свяжитесь с нами по e-mail: |
Вас категорически не устраивает перспектива безвозвратно исчезнуть из этого мира? Вы не желаете закончить свой жизненный путь в виде омерзительной гниющей органической массы пожираемой копошащимися в ней могильными червями? Вы желаете вернувшись в молодость прожить ещё одну жизнь? Начать всё заново? Исправить совершённые ошибки? Осуществить несбывшиеся мечты? Перейдите по ссылке: «главная страница».
|
© Ordo Deus, 2010. При копировании ссылка на сайт http://www.ordo-deus.ru обязательна. |